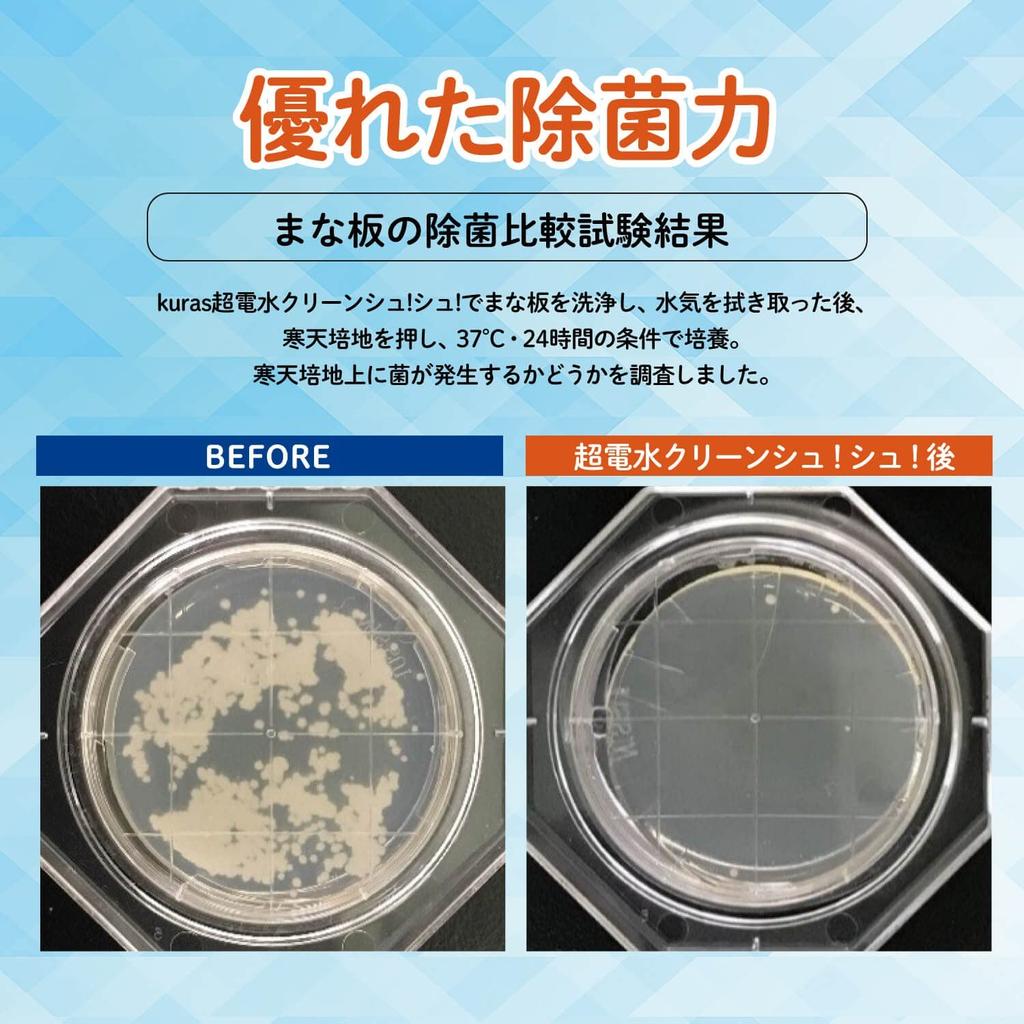

Dein Browser unterstützt die Seite nicht. Bitte aktualisiere deinen Browser oder lade einen anderen herunter
Kuras Klasse Elektrolytisches Alkalisches Reinigungswasser Super Elektrisches Wasser Reinigen 500ml Reinigung Sterilisation Hergestellt von Chemicoat Shu! Shu!
Aktueller Preis
Preis 74 €inklusive MwSt.
Preis 1,48 € / 10 ml
Lieferung innerhalb von 🇦🇹 Österreich
Lieferung 10‑31 Werktage
Sichere Zahlungen und Datenschutz









Ähnliche Produkte

![Tomowa Super Wasserabweisend 500 ml. Tipo's Abwehrmittel! [Artikel]](https://img.joomcdn.net/e57989e763601860a2b2e7ec593a07094b01da07_100_100.jpeg)








![Kao Küchenschaum Hyter Ersatz 1000 ml für gewerbliche Küche Kao Professional Services [Große Kapazität] Verwendung, Verwendung, Chlor, Desinfektion,](https://img.joomcdn.net/06ab9a8adef599e954f47b5f0ba8e365394564cc_100_100.jpeg)


